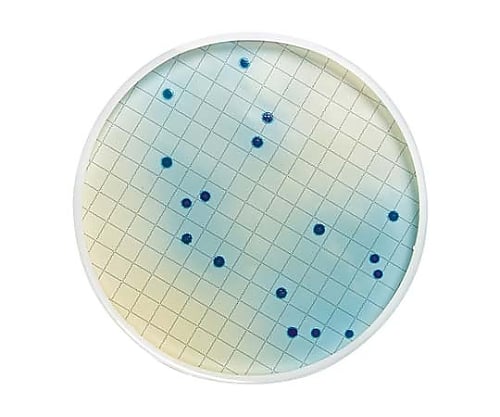

水 500ml 48本 ミネラルウォーター 天然水 送料無料 富士山の天然水 富士山の天然水500ml ラベルレス 天然水 バナジウム バナジウム含有 防災 備蓄 アイリスオーヤマ

定義域に制限がある場合の最大と最小|看護受験の必須 数学の公式を確認テスト : vol25
![[型番:22092913003930]【2022AW】SLOBE IENA【PIENI/ピエニ】2018年スタート。馬具屋出身のバッグブランド。「PIENI」はフィンランド語で「小さい」を意味し、全ての工程、縫製回数、ミニマルなサイズデザインで表現しています。「素材の良さ」を最小限の構成で最大限に表現するものづくりをし、必須なのは立体的に「技術」を表現すること。こちらの商品は、SLOBE IENAでの取り扱いになります。直接店舗へお問い合わせの際はSLOBE IENA店舗へお願い致します。※メーカー品番SZB-36-5061※カラーについて弊社販売カラー:メーカーカラーグレーA(007):HARMAA※照明の関係により、実際よりも色味が違って見える場合があります。またパソコン・スマートフォンなどの環境により、若干製品と画像のカラーが異なる場合もございます。予めご了承ください。](https://image.0101.co.jp/12208/img/cc00778339/cc007-78339-01b.jpg?basethum=460)
[型番:22092913003930]【2022AW】SLOBE IENA【PIENI/ピエニ】2018年スタート。馬具屋出身のバッグブランド。「PIENI」はフィンランド語で「小さい」を意味し、全ての工程、縫製回数、ミニマルなサイズデザインで表現しています。「素材の良さ」を最小限の構成で最大限に表現するものづくりをし、必須なのは立体的に「技術」を表現すること。こちらの商品は、SLOBE IENAでの取り扱いになります。直接店舗へお問い合わせの際はSLOBE IENA店舗へお願い致します。※メーカー品番SZB-36-5061※カラーについて弊社販売カラー:メーカーカラーグレーA(007):HARMAA※照明の関係により、実際よりも色味が違って見える場合があります。またパソコン・スマートフォンなどの環境により、若干製品と画像のカラーが異なる場合もございます。予めご了承ください。

海洋国家構想を掲げたジョコ政権は歴代の政治指導者とは異なり、軍近代化プロセスを加速させる意思と財源を示そうとしている

【ふるさと納税】【配送方法が選べる】ミネラルウォーター 水 500ml(通常便:25・40・50本 /定期便:25本or40本or50本×3〜6回・計75~300本) 天然アルカリ温泉水 財寶温泉…

営業の概況:タイヤ事業 プレゼン EAGLE-CAD 基板設計 20% OFF - Life Technologies - 1 - Ⅰ.体外受精技術(In vitro fertilization, IVF) 1.生殖細胞の形成 1 ヒューマンエラーを考慮したリスクアセスメント kaiin_page_mihon - 一般社団法人 福島県中小企業診断協会 ダウンロード 導入事例 株式会社 テイチクエンタテインメント様 IBM® Powerサーバーと Paperzz.comYour Paperzz

狂人にょっき 気まぐれゲーム記録「ファミコン版ドラクエ3 最小必須アイテム縛り ~1~」

【ふるさと納税】 【定期便】 天然水 水 2L 3ヶ月~12ヶ月 選べる本数 6本 12本 サントリー 南アルプス ナチュラル ミネラルウォーター 定期便 白州 防災 備蓄 仕送りギフト h009

【ふるさと納税】 ◆北海道の天然水 【 選べる お届け回数 】 単品 2ヶ月 3ヶ月 定期便 いろはす ラベルレス 2L 2箱 12本 セット 24本 36本 い・ろ・は・す 2000ml…

Gene Transfection toward Spheroid Cells on Micropatterned Culture Plates for Genetically-modified Cell Transplantation

【ふるさと納税】水 サントリー天然水 24本×1箱 計24本 550ml 奥大山 SUNTORY ナチュラル ミネラルウォーター 軟水 産地直送 送料無料 500ml+50ml 500…

Incident ID: c2ba82fd-bohn-49a7-b4e7-423b0c0aa8a2 IP Address : 219.104.25.38

Incident ID: e96a2577-bohn-438b-862a-ca31b32956ca IP Address : 219.104.25.38

【ふるさと納税】【配送方法が選べる】飲む温泉水 温泉水99 1.9L(通常便:計12~60本/定期便:12本×5〜12回 or 24本×5回・計60~144本)水 ミネラルウォーター 温泉水…

Incident ID: 8d6234ba-bohn-4a11-9236-7af483f58ff1 IP Address : 219.104.25.38

【ふるさと納税】【最短発送】黒松内銘水 水彩の森 2L 選べる6本(1箱)・12本(2箱)・24本(4箱) 北海道 ミネラルウォーター天然水 水彩の森 水 国産 国内 硬水 中硬水 ナチュラル…

RA - New Engagement Custom Widget 1.png

f:id:milktogogo:20181211202012p:plain

BIYOUDO 水 シリカ水 500ml×42本 350ml×48本 ナチュラルミネラルウォーター ラベルレス 軟水 美容ミネラル シリカ含有 天然水 シリカウォーター 保存料なし…
Incident ID: 5831c492-bohn-4ef7-9fcf-48efa1feda5b IP Address : 219.104.25.38

【ふるさと納税】\発送時期が選べる/ 富士山蒼天の水 <ラベルレス> 500ml×96本(4ケース) 第1位 天然水 ミネラルウォーター 水 シリカ ランキング 防災 備蓄 高評価 人気 年内発送…

10-10九州大学2019年度理系数学1番Ⅲ定積分、最小、極限_page-0001
![アサヒ おいしい水 天然水 シンプルecoラベル(24本入×2セット(1本600ml))【おいしい水】[ミネラルウォーター 天然水]](https://thumbnail.image.rakuten.co.jp/@0_mall/soukaidrink/cabinet/135/600135.jpg?_ex=300x300)
アサヒ おいしい水 天然水 シンプルecoラベル(24本入×2セット(1本600ml))【おいしい水】[ミネラルウォーター 天然水]

大腸菌培養用調製済み培地と原料(ForMedium社)
E. coli培養用培地/培地原料

【送料無料※一部地域除く】【48本】 水 500ml 蛍の郷の天然水 ミネラルウォーター 友桝飲料 ペットボトル 48本 2ケース

「食品衛生学実験」 vol.10 ~大腸菌群の分離②(定性試験)、推定試験の結果~

イーグルクランプ U字溝・溝蓋・縁石用クランプ UGHA型 UGHA-200

【ふるさと納税】 【定期便】 い・ろ・は・す 天然水 540ml 24本 選べる 3か月 6か月 12ヶ月 北杜市白州産 水 飲料 飲料水 ミネラルウォーター コカコーラ いろはす ペットボトル…

【ふるさと納税】水 2L 【定期便 あり】嬬恋の 天然水 ラベルレス ボトル 2L × 10本 入× 1~3箱 毎月 隔月 ミネラルウォーター 定期便 あり 飲料水 2000ml 2リットル 通販…

微生物の運動性とエネルギー生産の協調的制御機構を同定~微生物の病原性の理解や物質生産への応用に期待~